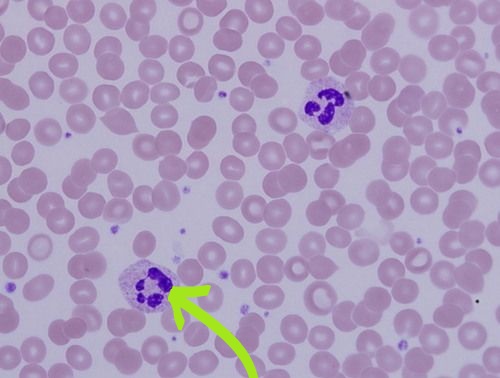

Иммунология зачёт

Список вопросов теста
Вопрос 1
Укажите препарат и название клетки, отмеченной стрелкой:
Варианты ответов
- честное пионерское, это красный костный мозг! а в нем сегментоядерный нейтрофил
- мамой клянусь, мазок крови! и лапочка-базофил
- вы в себе? это же биоптат лимфоузла. с NKT клеткой
- я, конечно, не гематолог, но это вроде бы кровь.. а в ней либо сегментоядерный нейтрофил, либо инопланетная собака с маской для сна...
Вопрос 2
Что бы вы вставили на место пропуска?

Варианты ответов
- Биг Мак
- Двойной чизбургер
- Биг Тейсти
- Мамину котлетку!
Вопрос 3
А что, собственно, выделится?

Варианты ответов
- гистамин
- тромбоксан А2
- брадикинин
- липидгидропероксидглутатионпероксидаза
Вопрос 4
Ну, хорошего понемножку. Теперь работаем!
Th1 участвуют в защите организма от:
Варианты ответов
- внутриклеточных патогенов
- бактериальных токсинов
- гельминтов
- опухолей
- алиментарных аллергенов
Вопрос 5
Какой из перечисленных цитокинов НЕ является провоспалительным?
Варианты ответов
- ИЛ1
- ИЛ6
- ИЛ8
- ИЛ10
- ФНО-альфа
Вопрос 6
Агаммаглобулинемия связана с отсутствием иммунокомпетентных клеток
Варианты ответов
- тучных клеток
- нейтрофилов
- плазматических клеток
- цитотоксических лимфоцитов
Вопрос 7
Дефект гена ИЛ-7 приведет к развитию
Варианты ответов
- аутоиммунной патологии
- первичного иммунодефицита
- аллергопатологии
- вторичного иммунодефицита
- не вызовет видимых изменений
Вопрос 8
Какой иммунологический метод можно использовать для определения чистой популяции иммунокомпетентных клеток?
Варианты ответов
- полимеразная цепная реакция
- проточная цитофлюориметрия
- иммуноферментный анализ
- секвенирование
Вопрос 9
Критерий диагностики Х-сцепленной агамаглобулинемии
Варианты ответов
- гипергаммаглобулинемия
- снижение IgA, IgG и повышение IgM
- тромбоцитопения
- количество В-клеток <2%
Вопрос 10
К тестам оценки иммунного статуса второго уровня относится:
Варианты ответов
- определение количественного содержания IgG в сыворотке крови
- определение пролиферативной активности Т-лимфоцитов
- определение абсолютного и относительного числа лимфоцитов
- количественное определение субпопуляций Т-лимфоцитов
Вопрос 11
Аллергенспецифическую иммунотерапию (АСИТ) проводят при
Варианты ответов
- поллинозе
- аутоиммунном тиреоидите Хашимото
- рассеянном склерозе
- сывороточной болезни
Вопрос 12
В тимусе происходят:
Варианты ответов
- Антителообразование
- Развитие Т-лимфоцитов хелперов 1 (Th1) и 2 (Th2) типов
- Развитие CD4+ и CD8+ Т-клеток
- Развитие тучных клеток
- Перегруппировка генов Т-клеточного рецептора
Вопрос 13
Антитела класса IgG обладают способностью
Варианты ответов
- Образовывать иммунные комплексы
- Активно переходить в секреторные жидкости
- Переходить через плаценту от матери к плоду
- Активировать комплемент
Вопрос 14
При связывании АТ с Fc-рецепторами на клетках врожденного иммунитета может происходить:
Варианты ответов
- образование поры в клетке
- активация системы комплемента
- привлечение Т-лимфоцитов
- фагоцитоз
Вопрос 15
Физиологические функции МНС:
Варианты ответов
- Представление антигенов Т лимфоцитам
- Представление антигенов В лимфоцитам
- Взаимодействие клеток иммунной системы
- Тканевая несовместимость
Вопрос 16
Какие клетки экспрессируют на своей поверхности молекулы MHC II класса?
Варианты ответов
- эритроциты
- клетки ворсинчатого трофобласта
- дендритные клетки
- клетки роговицы глаза
- активированные макрофаги
Вопрос 17
Механизм активации системы комплемента по альтернативному пути связан:
Варианты ответов
- с активацией специфическими сахарами бактериальной мембраны
- с участием комплекса антиген-антитело
- с активацией цитокинами естественных киллеров
- с активацией каскада каспаз
- с активацией продуктами фагосом активированных фагоцитов
Вопрос 18
Т-клетки в тимусе подвергаются процессам отрицательной селекции
Варианты ответов
- В мозговой зоне тимуса
- При контакте с клетками-«няньками»
- В субкапсулярной области тимуса
- В кортикальном эпителии
- При контакте с дендритными клетками тимуса
Вопрос 19
Какой цитокин проявляет супрессорные свойства?
Варианты ответов
- ГМ-КСФ
- ИЛ-1
- ИЛ-10
- Простагландин Е
Вопрос 20
Какие цитокины являются эндогенными пирогенами (положительно влияют на температуру тела)?
Варианты ответов
- ИЛ-2 и ИЛ-4
- ИЛ-1 и ФНО-альфа
- Хемокины
- ИЛ-7 и ИЛ-10
- Интерферон-альфа и интерферон-гамма
Вопрос 21
Последовательность синтеза антител в эффекторной фазе гуморального иммунного ответа:
Варианты ответов
- IgG→IgM→IgA→IgE→IgD
- IgM→IgG→IgA→IgE
- IgM→IgA→IgG→IgE
- IgA→IgM→IgG→IgE
- IgE→IgD→IgA→IgM
Вопрос 22
Преимущественно по I типу гиперчувствительности развиваются:
Варианты ответов
- кожная реакция на туберкулин
- аутоиммунная гемолитическая анемия
- атопический дерматит
- атопическая бронхиальная астма
- реакция отторжения гомотрансплантата
Вопрос 23
Преимущественно по II типу гиперчувствительности развиваются:
Варианты ответов
- сывороточная болезнь
- аутоиммунный лекарственный агранулоцитоз
- атопическая бронхиальная астма
- аутоиммунная тромбоцитопения
- реакция отторжения гомотрансплантата
Вопрос 24
Характерные особенности гаптена, в отличие от антигена:
Варианты ответов
- молекулярная масса 10000 дальтон и менее
- молекулярная масса 50000 дальтон и более
- имеет 1-2 антигенные детерминанты
- имеет 5-10 и более антигенных детерминант
- является иммуногеном
- становятся иммуногенами после соединения с белками организма
Вопрос 25
Верными являются утверждения:
Варианты ответов
- При атопии вырабатываются IgE-антитела
- При атопии комплексы антиген-антитело не активируют комплемент
- При атопии антитела после фиксации на клетках вызывают их повреждение
- При атопии антитела обладают способностью фиксироваться на тучных клетках и базофилах крови
Вопрос 26
Свойства тучных клеток:
Варианты ответов
- обнаруживаются в циркулирующей крови
- обнаруживаются в корковой части лимфоузлов
- дифференцируются в плазматические клетки
- вырабатывают гистамин
- несут на своей поверхности рецепторы для комплемента
Вопрос 27
Назовите первичные иммунодефициты:
Варианты ответов
- врожденный дефект дифференцировки стволовых кроветворных клеток
- синдром приобретённого иммунодефицита в детском возрасте
- агаммаглобулинемия (синдром Брутона)
- гипоплазия тимуса (синдром Ди-Джорджи)
- синдром Клайнфельтера
Вопрос 28
Для заражения ВИЧ необходимо наличие на поверхности клетки:
Варианты ответов
- рецептора для ИЛ-2
- CD4
- CD8
- CD3
- CD17
- CD19
- всех перечисленных CD
Вопрос 29
Для гиперчувствительности замедленного типа характерно:
Варианты ответов
- в механизмах развития основную роль играют Тh1 и макрофаги
- в механизмах развития основную роль играют реагины
- главными медиаторами являются лимфокины
- кожная реакция на специфический антиген выражена через 20-30 мин
- кожная реакция на специфический антиген выражена через 24-48 час
Вопрос 30
Каким иммунодефицитом был болен Дэвид Веттер ("мальчик в пузыре")?
Варианты ответов
- тяжелым комбинированным иммунодефицитом
- синдромом приобретенного иммунодефицита
- синдромом Луи-Бар
- синдромом гипер-IgE
Получите комплекты видеоуроков + онлайн версии
 0
0 435
435 Нравится
0
Нравится
0

 Создать тест
Создать тест Вход
Вход








